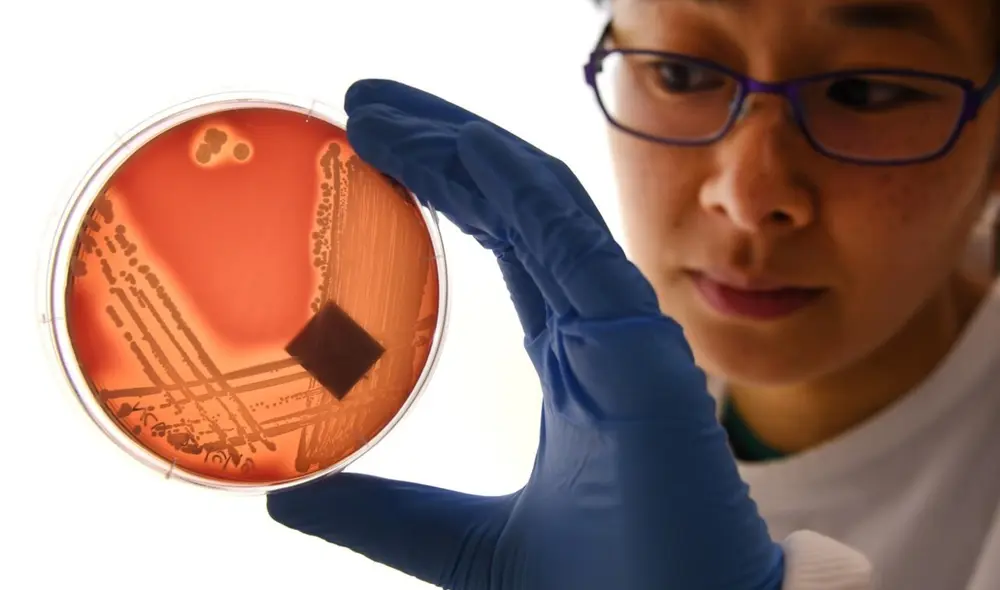
Los científicos continúan demostrando la eficacia de una terapia con virus que permite aniquilar bacterias que han adquirido resistencia a los antibióticos. Foto: AFP

Terapia con virus salva a un hombre de bacteria invencible a todos los antibióticos
El caso demuestra la eficacia de este revolucionario método para tratar infecciones de superbacterias, muchas de ellas mortales y sin cura alguna.
- La NASA descubre moléculas de ARN en el asteroide Bennu que explicarían el origen de la vida
- Los astrónomos se sorprenden: detectan en la superficie del cometa 3I/ATLAS unas erupciones ‘volcánicas’ pero de hielo
La aparición de bacterias resistentes a nuestro arsenal de antibióticos es un problema de salud pública que podría catalogarse como una pandemia oculta. Según un informe de este año de la revista The Lancet, dichas infecciones causan más muertes al año que otras enfermedades mortales como el sida y la malaria.
Por suerte, los científicos continúan demostrando la eficacia de una terapia alternativa que consiste en emplear virus especializados en matar a cada bacteria mortal. Estos patógenos son conocidos como bacteriófagos y se cree que cada uno puede cumplir la tarea de aniquilar una bacteria específica.
En un artículo publicado en la revista Nature, un equipo de médicos de Estados Unidos, liderado por la médica Jessica Little, detalla cómo un hombre se salvó con este método luego de que todos los antibióticos fallaran en controlar una infección por Mycobacterium chelonae, una bacteria de la familia de la tuberculosis.
El paciente de 56 años presentaba erupciones y llagas en la piel que se extendieron por el brazo izquierdo y que, tras un año de terapia con antibióticos, incluso habían empeorado. Además, desarrolló efectos secundarios por la toxicidad de los antibióticos.

Imágenes de las lesiones del paciente antes del tratamiento con el virus Muddy (foto de la izquierda superior) y ocho meses después de este (izquierda inferior). Foto: Jessica S. Little, et. al. (2022)
Ante ese escenario, los médicos extrajeron microbios de las heridas del paciente, secuenciaron su genoma y evaluaron qué fago podría eliminar a M. chelonae. Así se seleccionaron a Muddy, quien cumplía dichas condiciones en las pruebas de laboratorio.
La terapia con este virus se ejecutó de manera intravenosa en la paciente; paralelamente al uso antibióticos. Esto se cumplió durante un periodo de seis meses, pero las lesiones mejoraron significativamente en apenas dos semanas, detalla el artículo.
Si bien el paciente generó anticuerpos contra el virus Muddy, no tuvo complicaciones ni recaídas.
Por el momento, los tratamientos con ‘virus come bacterias’ son el último recurso cuando no existen más opciones terapéuticas contra las infecciones bacterianas. Sin embargo, estudios esperanzadores como este refuerzan su uso potencial en etapas previas de una infección grave.
“Recurrir a bacteriófagos como tratamiento compasivo no es nuevo, pero el hecho de que cada vez haya más casos y con resultados positivos refuerza la necesidad de regular su utilización en clínica”, resalta la bióloga española Pilar Domingo-Calap para una entrevista en El País.
“Necesitamos comprender mejor la interacción entre estos virus y el sistema inmune de los pacientes, y si esta puede afectar al éxito del tratamiento”, añadió.

Las bacterias pueden adquirir una resistencia por el uso indiscriminado de los antibióticos. Foto: Daniel González
















